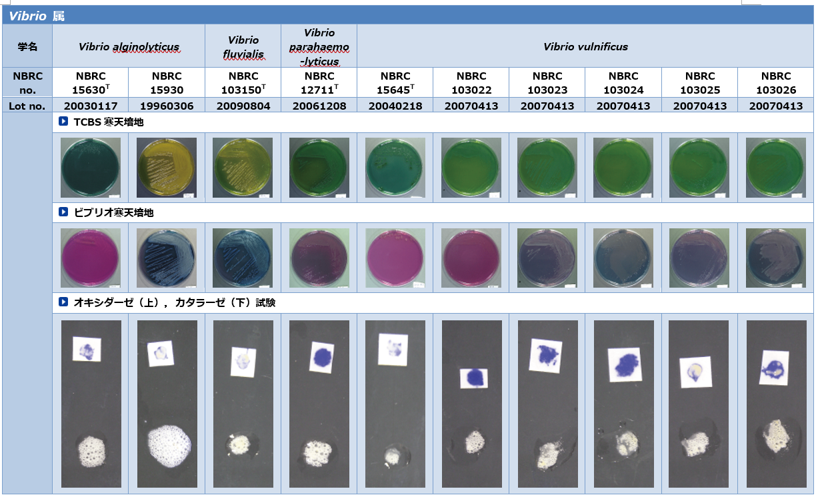
食品衛生検査指針に基づく性状試験結果 Vibrio 属

食品衛生法上使用される大腸菌等の性状調査
食品の汚染状況や施設・設備の衛生管理の適否を客観的に評価するための指標となる菌種から、大腸菌、サルモネラ菌、ビブリオ属細菌について、食品衛生法に規定される培地上での性状を調査しました。
試験方法
「食品微生物検査マニュアル《新版》」(栄研器材株式会社)に記載されている方法を参考にして、下表に示すNBRC株を用いて試験しました。使用培地は菌種毎に異なるため、各試験結果を示した PDFに記載しています。
(第十五改正日本薬局方 培地性能試験に使用される大腸菌等の性状調査の結果に関しては、こちらをご参照ください。)
供試菌株
| 学名 | NBRC番号 | Lot No. |
|---|---|---|
| Escherichia coli | NBRC 3301 | 20060808, 20060809, 20060811 |
| NBRC 3972 | 20110118, 20110126, 20110201 | |
| NBRC 13168 | 20110121 | |
| NBRC 13892 | 19790320 | |
| NBRC 102203T | 20071207 | |
| Salmonella enterica subsp. enterica serovar. Abony | NBRC 100797 | 20080207, 20080208 |
| Salmonella enterica subsp. enterica | NBRC 3313 | 19980114 |
| NBRC 13245T | 20060210, 20060215, 20060216 | |
| Vibrio alginolyticus | NBRC 15630 | 20030117 |
| NBRC 15930 | 19960306 | |
| Vibrio fluvialis | NBRC 103150 | 20090804 |
| Vibrio parahaemolyticus | NBRC 12711 | 20061208 |
| Vibrio vulnificus | NBRC 15645 | 20040218 |
| NBRC 103022 | 20070413 | |
| NBRC 103023 | 20070413 | |
| NBRC 103024 | 20070413 | |
| NBRC 103025 | 20070413 | |
| NBRC 103026 | 20070413 |
試験菌株の性状試験結果
各試験結果の画像はPDFをダウンロードしてご確認ください。
「第十五改正日本薬局方特定微生物試験に基づく培地性能試験」における同等の試験の結果についてはこちらにてご確認ください。
Escherichia coli

Salmonella enterica
試験菌株の性状試験結果画像:Salmonella enterica [PDF:1613KB]

Vibrio 属
試験菌株の性状試験結果画像:Vibrio 属 [PDF:1845KB]
2019年7月更新
PDFファイルをご覧いただくためには、Adobe Reader(無償)が必要です。Adobe Readerはダウンロードページ
よりダウンロードできます。
お問い合わせ
-
独立行政法人製品評価技術基盤機構 バイオテクノロジーセンター
生物資源利用促進課
(お問い合わせはできる限りお問い合わせフォームにてお願いします) -
TEL:0438-20-5763
住所:〒292-0818 千葉県木更津市かずさ鎌足2-5-8 地図
お問い合わせフォームへ








